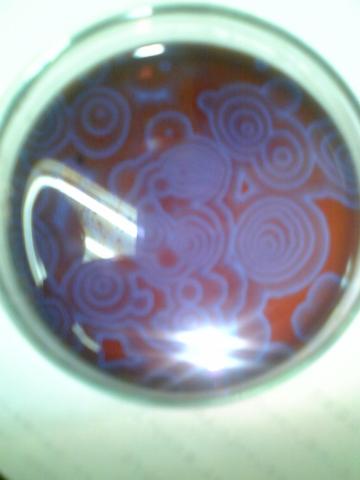

のレビューでやっと君が確かに理系学生やってるのかもしれない気がしたよ。
けど、それだけじゃやっぱり納得いかないな。証拠を見せてよ!
と言っているそこの貴方!
本日はマッドサイエンティストの三種の神器を見せて差し上げましょう!
(゚д゚)!初めて聞いたよと思った貴方!
今作ったばかりなのでそのはずです!!
これは、見ての通り試験管と試験管立てと攪拌棒です。
といっても実は私が化学をやっていたのは
高校の時で今は化学は専門じゃありませんw
あの頃は、理化学部というところで週に4回くらい実験をやっていました。
使い方はわかりますよね?
理系の強者たちは試験管で飲み物を飲んだりしています。
攪拌棒もあるのでビーカーを持ってくればカクテルも作りやすいですよw
今回はサービスということで、
昨年話題になったBZRの写真を掲載しておきましょう。
当時高校生だった私が撮影した写真です。
私も、実験放置してカラオケに行くような
不真面目な生徒だったら大発見をしていたかもしれません。(笑)
-
購入金額
0円
-
購入日
2006年07月頃
-
購入場所
東急ハンズ

ちゃなさん
2012/01/17
お茶やコーヒーが半端なく美味しく濃く出ますよ。(もちろん純水をそのまま飲用にするのは止めた方が良いです)
ちなみに試験管で飲み物は飲みません。ビーカーをタンブラー代わりにする事はある。大きめのビーカーはカクテルのサーバーになる。
でも、このあたりはみんなやってるし普通ですよ?
マッドテキーはそんなの有っても無くても関係無いのです。うはは(^^ゞ
TakOnuさん
2012/01/17
純水製造装置ですか。懐かしいですな。
今は陽イオン交換樹脂と陰イオン交換樹脂を買って
直接水道水にぶち込むのが限度ですね。
純水製造装置は高いですからねぇ。
そして、純水は美味しくないので……もうそのまま飲むことはないでしょう……。
高校時代経験済みですw
コーヒーはやってみますかね。
久しぶりに交換樹脂を扱うとなるとなんだかワクワクしてきました。
そして、私も高校の時は一リットルビーカーとか使ってラーメンを食べていましたw
>マッドテキーはそんなの有っても無くても関係無いのです
いやぁ、まったくもってそのとおりですわw
ちゃなさん
2012/01/17
TakOnuさん
2012/01/17
久しぶりにワクワクですw